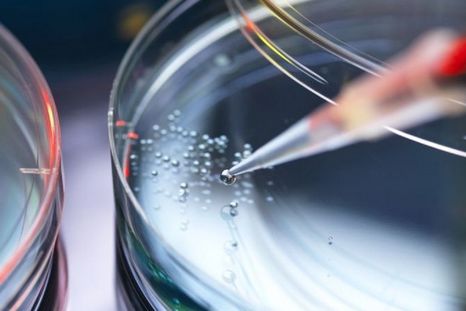

BBC
Investigación

Papelón acá y en el mundo

Misión espacial

Economía

Misión espacial

Pandemia

Pandemia